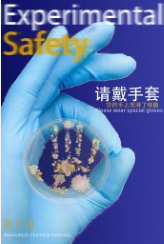

关于公示“智绘安全·守护未来”第一届实验室安全海报设计大赛获奖入围名单的通知
发布时间:2024-12-10
浏览次数:263
各相关学院:
为深入学习贯彻习近平总书记关于总体国家安全观的重要论述精神,全面落实党中央、国务院关于做好高校实验室安全工作的部署要求,大力弘扬实验室安全文化,提高实验室安全管理能力和水平,切实保障校园安全稳定和师生生命财产安全。我校于11月初面向全校征集实验室安全海报设计作品,共征集118位个人/团队提交的175份作品。经过设计专家、实验室管理专家两轮严格、公正的评选,现将拟获奖入围名单及作品公示如下:
序号 | 参赛者 | 学院 | 作品 |
1 | 王俊哲 黄瑞祺 | 前沿软物质学院 未来技术学院 |
|
2 | 张子涛 | 自动化科学与工程学院 |
|
3 | 张旸 | 材料科学与工程学院 |
|
4 | 李杨云 袁思雨 钟绮桦 | 材料科学与工程学院 |
|
5 | 候雅茜 | 设计学院 |
|
6 | 方如萍 | 外国语学院 |
|
7 | 汤美如 王馨鹤 | 材料科学与工程学院 |
|
8 | 郑燕 罗嘉盈 | 材料科学与工程学院 |
|
9 | 罗颖 | 海洋科学与工程学院 |
|
10 | 汪子阳 | 化学与化工学院 |
|
11 | 陈柏瑶 | 设计学院 |
|
12 | 董诗语 罗婉荧 | 设计学院 |
|
13 | 夏晨希 | 设计学院 |
|
14 | 朱天睿 | 设计学院 |
|
15 | 丁禾 | 材料科学与工程学院 |
|
16 | 萧浩林 | 材料科学与工程学院 |
|
17 | 刘祎璇 | 材料科学与工程学院 |
|
18 | 张家惠 | 化学与化工学院 |
|
19 | 陈星宇 | 建筑学院 |
|
20 | 杨可凡 | 前沿软物质学院 |
|
21 | 黄禹臻 | 设计学院 |
|
22 | 周之涵 | 设计学院 |
|
23 | 叶向阳 | 设计学院 |
|
24 | 郭靖怡 | 生物科学与工程学院 |
|
25 | 陈嘉烨 | 食品科学与工程学院 |
|
26 | 宋瑞洋 | 食品科学与工程学院 |
|
27 | 张祥卓 | 土木与交通学院 |
|
28 | 陈睿雪 王璐璐 | 土木与交通学院 化学与化工学院 |
|
29 | 夏新洋 | 土木与交通学院 |
|
30 | 潘睿淇 | 新闻与传播学院 |
|
公示期为2024年12月9日至12月12日,公示期间对入围作品有异议,请实名发送邮件至邮箱:202320162149@mail.scut.edu.cn,或联系曾老师:020-81181717反映。
华南理工大学实验室与设备管理处
华南理工大学前沿软物质学院
2024年12月9日